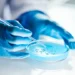
بكتيريا متجمدة منذ آلاف السنين تثير آمالاً طبية ومخاوف صحية

حرية | الاربعاء 18 شباط 2026
وليد فارس
بعد سقوط آلاف القتلى وتوقيف الآلاف بتهمة المشاركة في تظاهرات إيران من قبل النظام، اشتعلت التظاهرات الضخمة بالمدن الكبرى في “العالم الحر” منددة بالسلطة في طهران ومطالبة باستبدالها، وفي الوقت نفسه أعلنت واشنطن أنها منغمسة جدياً في سعي جديد لإيجاد صفقة مع القيادة الإيرانية لتفادي الحرب المباشرة، وبدأت جلسات اجتماع بين طهران ومبعوثي الإدارة الأميركية في دول عدة، وربما الأهم هو حشد عسكري هائل للولايات المتحدة في المنطقة ولا سيما منطقة الخليج وبحر العرب والمحيط الهندي، ماذا يعني كل ذلك وهل هنالك معادلة جديدة بين واشنطن وإيران؟
كما كتبنا مراراً هنالك قابلية لدى الرئيس ترمب من ناحية والنظام الإيراني لعقد صفقة ما في الأقل لمنع حدوث حرب بين الطرفين، لكن تبين أن للطرفين تصوراً مختلفاً لأي اتفاق، فالنظام يسعى إلى عقد اتفاق شبيه للاتفاق النووي لعام 2015 لكن مع رئيس أميركي غير الرئيس السابق أوباما. طهران لا تعتزم القبول بتنازلات سيادية أو داخلية وتعتقد أن البيت الأبيض سيقبل بوثيقة تركز على اتفاقات اقتصادية أكثر منها سياسية إصلاحية، لكن دونالد ترمب، وإن أراد التوقيع على “أم الصفقات المالية” إلا أنه يدرك أن هنالك حدوداً موضوعية لأي اتفاق بينه وبين خامنئي والحرس الثوري. الحدود الأولى هي المواجهة بين إسرائيل والجمهورية الإيرانية، إذ إن توفير أولويات للجانب الإيراني على حساب إسرائيل سيصطدم بأصدقائها في واشنطن، في خلال سنة انتخابية بامتياز.
الحد الثاني للإدارة الأميركية هو الثورة الداخلية، فمن غير الممكن دولياً بعد مقتل الآلاف من المدنيين، أن تسمح واشنطن والعواصم الغربية بسقوط عشرات آلاف آخرين إضافية على مرأى من أعين الرأي العام العالمي، فكيف يمكن التوقيع على اتفاقات مالية أو أمنية وآلاف الإيرانيين من كل الطوائف والإثنيات يقتلون ومئات الآلاف من كل المجتمعات الإيرانية يعتقلون. من هنا التعقيد الأعمق لا يبدو أن له حلاً سريعاً، فالرئيس ترمب يحتاج إلى ضمانة عدم تصرف النظام بشكل دموي يسقط مشروعية أية صفقة في الداخل الأميركي والغربي ومن ثم لدى الداخل الإيراني، وخامنئي لا يريد استضعاف نظامه إلى حد تمكين واشنطن من إضعافه وإسقاطه.
ويبقى الوضع العسكري حيث نشرت واشنطن أسطولين مع حاملتي طائرات ومدمرات وسفن لوجيستية بحجم يضاهي القوة التي نفذت عملية كاراكاس في بداية العام العالي التوتر، لأن الحرس الثوري عبأ هو الآخر صفوفه ونشر منصات صواريخه الباليستية وبات جاهزاً للمواجهة. الطرفان لا يريدان القتال، لا المرشد العام ولا صاحب البيت الأبيض، كل طرف تقدم للمعركة أملاً في ألا تحصل، لكن الوضع الثوري في إيران سينفجر أياً كان الاتفاق أو عدمه والوضع الداخلي في أميركا قد ينفجر سياسياً مع اقتراب الانتخابات النيابية.
الضغط الدبلوماسي على الإدارة يتصاعد في المنطقة وفي الغرب لإجهاض الحملة الأميركية العسكرية إلا أن الأوروبيين بدأوا يتمنعون عن الضغط بسبب المجازر في الداخل الإيراني، مما يضع الإدارة في موقع نصفي بين قرار الصفقة وقرار الحرب. الرئيس والمبعوثون يأملون بصفقة قبل منتصف الليل مما يفسر محاولات ستيف ويتكوف وجاريد كوشنر للحصول على أي تنازل إيراني رسمي يعطي ترمب مادة لتطمين الأميركيين والحكومات في العالم بأن المواجهة غير ضرورية إذا تراجع النظام، وهذا الأخير يسعى إلى كسب الوقت كي لا يجبر على القبول بشروط تعجيزية قد تقود إلى انهيار تدريجي.
الانتشار العسكري الأميركي واسع بشكل يجعل المتخصصين يقتنعون بأن المعركة واقعة، فإضافة إلى حاملتي الطائرات هناك أساطيل صواريخ ومسيرات بإمكانها استهداف آلاف الأهداف داخل الجمهورية. وفي المقابل لدى الحرس الثوري أعداد من الصواريخ تستهدف الحاملات والمدمرات والسفن اللوجيستية، والتقدير أن مواجهة كهذه لن تنتهي إلا إذا قررت واشنطن الانسحاب بحال تعرضها لخسائر فادحة أو بتدمير كامل المواقع القيادية والاستراتيجية الإيرانية، وقد يكون السيناريو الأخير الأكثر واقعية لكن المفاجآت واردة.
ويبقى البعد الأخير وهو الاستعداد الشعبي للمواجهة مع النظام، مما حدث حتى الآن من تظاهرات وقمع حكومي وأعداد قتلى بالآلاف، فإن التكهن الأقرب هو أن المحتجين سيعاودون النزول إلى الشارع على رغم سقوط الضحايا لكن فرصهم بالانتصار على النظام سترتبط بعاملين، الأول هو مساعدة أميركية دولية والثاني وحدة صف المعارضة بقيادة حكومة انتقالية.